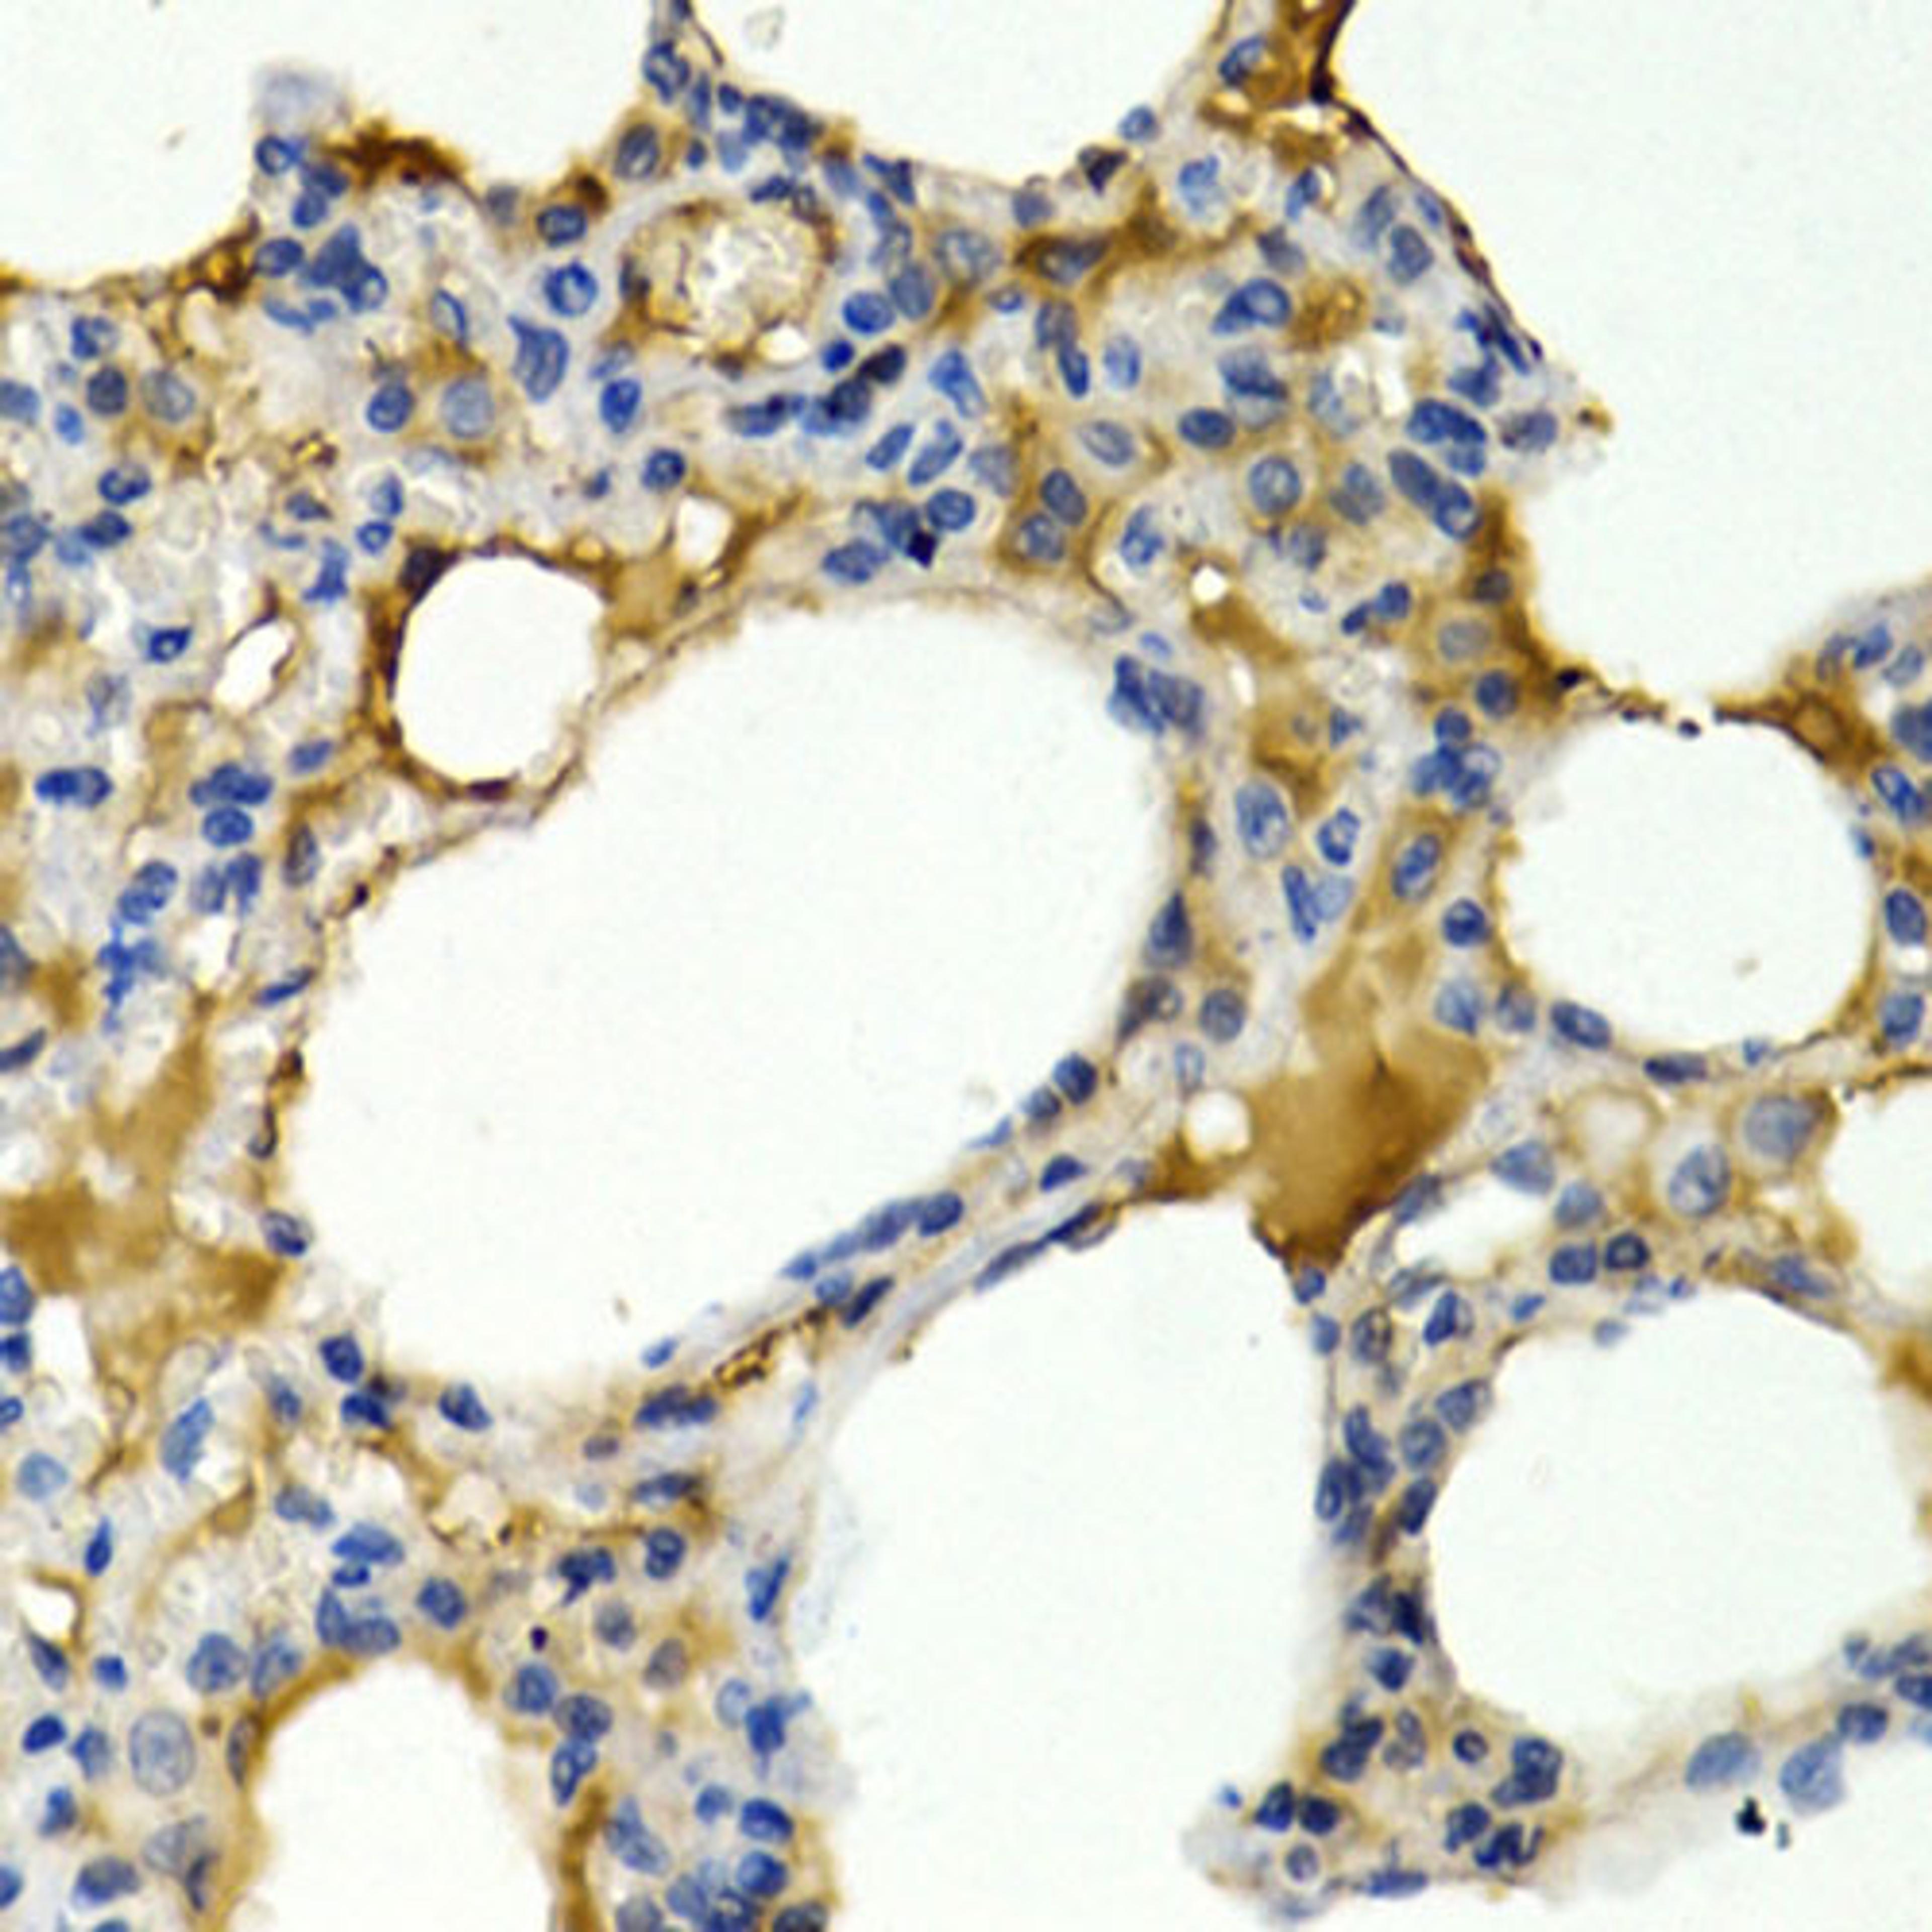
Immunohistochemistry - IL9 antibody (A1894)

IL9 Rabbit pAb
Product Details
- Cat. No.
- A1894
- Type
- Primary Antibody
- Clonality
- Polyclonal
- Host
- Rabbit

The supplier does not provide quotations for this antibody through SelectScience. You can search for similar antibodies in our Antibody Directory.
Description
The protein encoded by this gene is a cytokine that acts as a regulator of a variety of hematopoietic cells. This cytokine stimulates cell proliferation and prevents apoptosis. It functions through the interleukin 9 receptor (IL9R), which activates different signal transducer and activator (STAT) proteins and thus connects this cytokine to various biological processes. The gene encoding this cytokine has been identified as a candidate gene for asthma. Genetic studies on a mouse model of asthma demonstrated that this cytokine is a determining factor in the pathogenesis of bronchial hyperresponsiveness.
Biological Information
- Clonality: Polyclonal
- Host: Rabbit
- Reactivity: Human, Rat